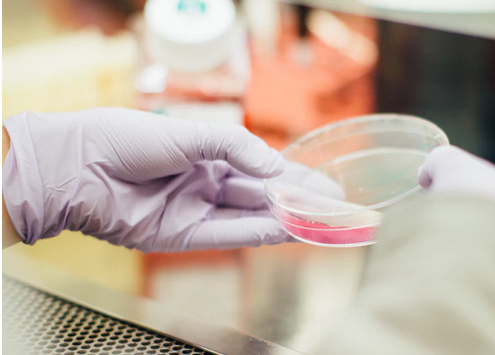

Пациенты часто путают эти две процедуры, иногда заменяя одно другим. На самом деле, существует большая разница между Ботоксом и Филлером, и знание этой разницы поможет Вам в выборе правильной процедуры именно для Вас.
I. Что такое БОТОКС?
Ботокс – это очищенный ботулинический токсин, вещество, получаемое из определенных бактерий. В медицине он используется для лечения некоторых мышечных проблем, а в эстетической медицине – для лечения и предотвращения морщин. Токсин замораживает мышцы, предотвращая появление морщин и складок, вызванных мимикой на лице.
Наиболее распространенные области инъекций
Ботокс часто вводят в области, особенно подверженные морщинам, из-за мимики лица. Таким образом, наиболее распространенными областями могут быть линии между бровями (так называемая “надпереносье”), горизонтальные линии на лбу, вокруг глаз или (так называемые “гусиные лапки”). Его также можно использовать для уменьшения объема на определенных участках лица, например, в области челюсти – для создания линии V.
Ботокс также можно вводить в кожу, чтобы добиться эффекта “стеклянной ” кожи. В этом случае ботулинический токсин вводится в наружный слой кожи, а не в мышцы. Эта процедура называется Skin Botox и дает мгновенный эффект светящейся и увлажнённой кожи, без необходимости сложных процедур по уходу за кожей. Данная процедура стала популярной среди корейских знаменитостей. Однако, эффект не длится долго, поэтому советуется делать данную инъекцию каждые 3-4 месяца.
Инъекции ботокса полностью обратимы и эффект обычной процедуры может длиться до 4 месяцев. Период наилучшего результата составляет около 1 месяца после процедуры.
Что нужно знать: Меры предосторожности после Ботокса
- Синяки: Когда игла шприца касается сосудов, могут возникнуть синяки, потому что под кожей проходят множество кровеносных сосудов. Однако, синяки обычно небольших размеров и исчезают в течении нескольких дней (3-5 дней), поэтому вам не нужно об этом беспокоиться.
- Процедура ботокса на лоб или надпереносье: существует вероятность блефароптоза, который является термином для трудности открытия глаз из-за слабых мышц глаз. Поэтому, пожалуйста, умывайтесь осторожно и аккуратно, не трите глаза после процедуры ботокса.
- Вы можете чувствовать тяжесть, когда открываете глаза после инъекции в лоб. Это случается у пациентов, которые склонны к частому использованию мышц лба.
- После инъекции ботокса вокруг глаз, вы можете чувствовать легкий дискомфорт, когда вы улыбаетесь в течение первых нескольких недель. Со временем это вернется к норме.
- После инъекции ботокса вокруг нижней челюсти, вы будете чувствовать дискомфорт, когда вы жуете твердую пищу, но вы привыкнете к ней в течении нескольких недель.
II. Что такое ФИЛЛЕР?
Существует много различных наполнителей, но наиболее распространенным веществом является гиалуроновая кислота – вещество, вырабатываемое самой кожей для поддержания ее баланса увлажнения.
Филлер используется как омолаживающая процедура для придания объема на лице в областях, которые мы хотим визуально увеличить. Наиболее распространенными областями инъекции являются носогубные складки, передние щеки, линии марионеток – с целью предотвращения старения, а также губы, переносица, подбородок, под глазами с целью увеличения объема.
Продолжительность эффекта больше, чем у ботокса, и может длиться до 9 месяцев или 1-го года, в зависимости от бренда.

Что нужно знать: Меры предосторожности после Филлера
- Сразу после процедуры могут появиться отеки, синяки и боль в местах инъекции. Это очень нормальное явление, которое исчезнет через несколько часов. Иногда это может длиться до нескольких дней.
- Если в течение нескольких часов боль станет сильной, немедленно посетите клинику. Если в зоне надпереносья и носогубных складках есть изменение цвета, пожалуйста, посетите клинику для проверки.
- Если вы продолжаете чувствовать боль и отек после нескольких дней, немедленно обратитесь к врачу.
- Пожалуйста, избегайте нанесения макияжа на место инъекции в день инъекции филлера.
- Не пейте алкоголь, так как это может вызвать отек и воспалительные реакции.
Преимущества и риски использования БОТОКСА и ФИЛЛЕРА
Ботокс и филлер имеют свои преимущества и риски. Прежде всего, вы должны помнить, что обращение к сертифицированному дерматологу или пластическому хирургу значительно уменьшит вероятность нежелательного эффекта или осложнений.
Выбор клиники, которой можно доверять, является решающим фактором для достижения желаемого и удовлетворительного результата. Центр Пластической Хирургии JW обеспечит Вам безопасную процедуру инъекции ботокса и гиалуроновой кислоты.
Записаться на бесплатную онлайн-консультацию можно тут
Ссылки
Skin Botox: Korean injectable technique for a glass skin, in: Allure.com; https://www.allure.com/story/skin-botox-korean-injectable-technique-glass-skin
Oxford Academic, Aesthetic Surgery Journal: A Review of OnabotulinumtoxinA, https://academic.oup.com/asj/article/33/1_Supplement/9S/211819
Oxford Academic, Aesthetic Surgery Journal: OnabotulinumtoxinA and Hyaluronic Acid in Facial Wrinkles and Folds: A Prospective, Open-Label Comparison, https://academic.oup.com/asj/article/39/2/187/4995056
